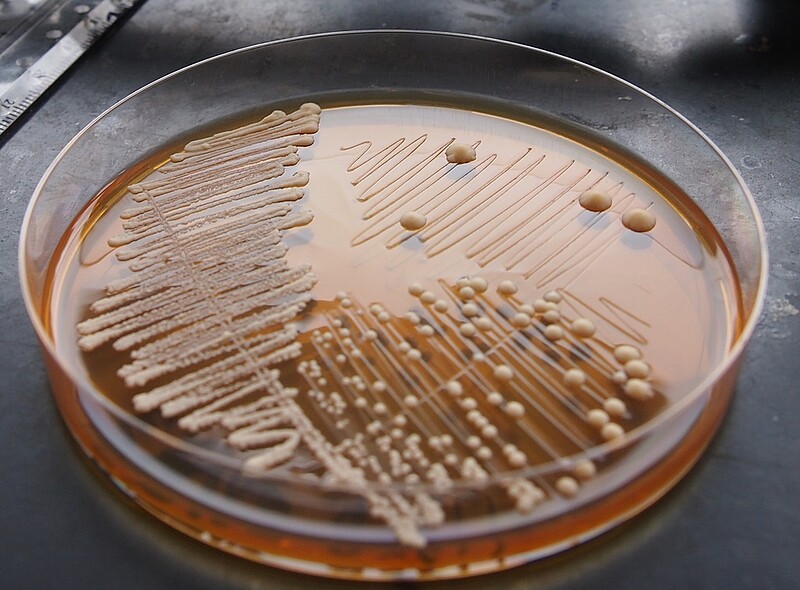

Actualités
Recherche, innovation, vie des campus : retrouvez toute l'actualité de l’Université de Strasbourg.

Toute l'actualité
Un nouveau pas dans la compréhension de l’origine génétique de la variation des caractères
112 collégiens réfléchissent sur l’avenir de l’Europe, à l'invitation de Sciences Po Strasbourg
Dossier multimédia des étudiants du Cuej : « Virage et pépins sur la route des vins »
Il était une fois, la jolie route des vins d'Alsace. Derrière le décor pittoresque, le glyphosate s'attaque aux vers de terre, reines des vins et ésotérisme se côtoient et la vigne du futur bourgeonne.
Trois questions à Rémi Barillon sur le nouveau contrat quinquennal
Ma Thèse en 180 secondes, 1er prix pour Sarah Silvère
Intelligence artificielle : vers un leadership européen et mondial grâce au projet Enact, lauréat de l’AMI IA Cluster
Université & société : un mouvement coordonné ?
QUSTEC, la fin d’un programme qui fait rimer éducation et innovation dans le domaine quantique
Prix Louise Weiss 2024 : les 6 lauréats du concours de littérature dévoilés
Mardi 14 mai, les 6 lauréats de l’édition 2024 du Prix Louise Weiss ont été annoncés. L'ensemble des étudiants de l'Université de Strasbourg avaient été invités pour cette 11e édition à composer des textes sur la thématique « L'enfance, tout un monde ».